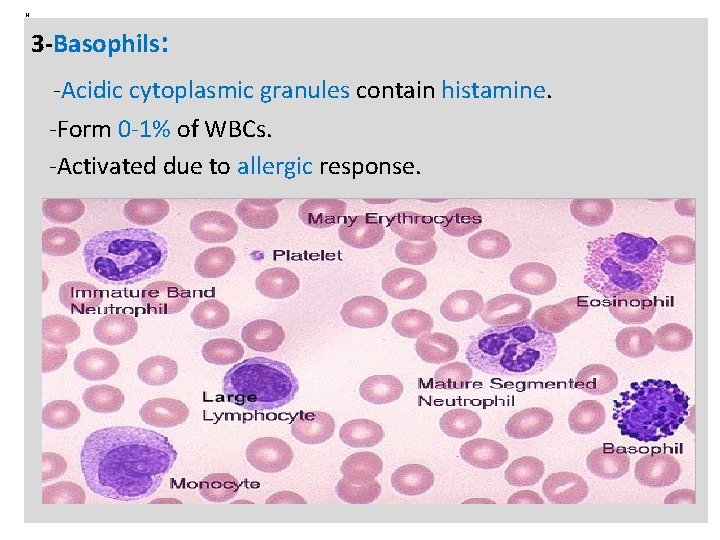
N 3 -Basophils: -Acidic cytoplasmic granules contain histamine. -Form 0 -1% of WBCs. -Activated

Immune cells Receptors and Markers White blood cells

Immune cells , Receptors, and Markers: White blood cells or leukocytes serve as defenders against infection. They move around the body via the lymphatic and blood circulatory systems, and can leave and reenter the circulation to move through body tissues.

N Leukocytes are classified according to their morphology, origin, and immunologic function into the following groups: 1 -Cells of Myeloid lineage: A-Granular leukocytes: Neutrophils, Eosinophils, and Basophils. B-Agranular leukocytes: Monocytes , and macrophages. 2 -Cells of Lymphoid lineage: A-Agranular leukocytes: T cell, B cell. B-Granular leukocytes: NK cell.

Leukocytes and Immune system: N

N Cells of Myeloid lineage: A-Granular leukocytes: 1 -Neutrophils or polymorphonuclear cells: -Form 60% of the peripheral blood leukocytes. -Metamyelocyte , juvenile (band) form, Stab form, and segmented (mature) form. -Very effective at killing bacteria. -Elevated number: mainly in acute bacteria infection. 2 -Eosinophils: -Eosin-loving granules. -form 0 -5% of WBCs. -Activated due to parasitic helminthes infection.
N 3 -Basophils: -Acidic cytoplasmic granules contain histamine. -Form 0 -1% of WBCs. -Activated due to allergic response.

N B-Agranular leukocytes: Monocytes , and macrophages: -Monocytes in the circulation, and macrophage in the tissues. -5 -7% of peripheral blood leukocytes. -Scavenger cells for innate immunity. -Antigen presenting cells (APC). -Macrophage markers: CD 14, CD 40, CD 11 b

Cells of Lymphoid lineage: A-Agranular leukocytes: Lymphocytes: - Immune system must be able to distinguish its own cells, and organs (Self) from those of foreign origin (nonself). - The innate immune cells depend on Pathogen recognition receptors (PRRs). -The adaptive immune cells utilizes somatically generated epitope-specific T and B lymphocyte receptors.

N According to type of receptor, and organs of differentiation (where they undergo basic training), Lymphocytes are classified into three groups: 1 -Thymus-derived cells (T-Cells): -Arise from Bone marrow as prothymocytes. -Enter the circulation from Thymus. -Identified by presence of CD 3 complex (TCR). -Two subsets: - CD 4⁺ T cells: Restricted to the recognition of MHC class II Complexes. - CD 8 ⁺ T cells: Restricted to the recognition of MHC class I complexes.

N 2 -Bone marrow-derived cells (B-Cells): -Remain and develop within bone marrow. -The precursors of Ig-producing lymphocytes. -Two types: B cells: -Arise from hematopoietic stem cells in B. M. -Have two different lineages: B 1, and B 2. -B 1 present in respiratory &GIT Systems. -B 2 widely distributed in lymphoid organs and tissues. -Ig. M and Ig. D present on both cells surface. -Isotype switching is typical for B 2 lineage. -Markers : CD 19, and CD 20.

N Plasma cells: - Terminally differentiated B cells. - Immunoglobulin producing cells. 3 -Natural killer cells (NK-Cells): -Forms 5 -10% peripheral blood lymphocytes. -Lack both T cell receptor and B cell receptor. -Very active in killing of Virally infected cells and Tumor cells. -Carry two receptors: Killer activation and inhibition receptors (KARs and KIR).

Immune cell(s) Receptors: -A wide variety of immune system activities is initiated by receptor-ligand interaction. - Different intracellular signals are generated due to activation of immune cell receptors. -The immune cell receptors are classified into two types: 1 -Preformed receptors: A-Pattern recognition receptors: : CRP, CD 14, C 3 b and MBP; recognize pathogen associated molecular patterns (PAMP). B-Toll-like receptors: Activated by binding to a PAMP.

Toll-like receptors and Recognition of PAMP: n

N C-The complement receptors: -C 3 b fragments bind to its receptors on Phagocytes and B lymphocytes. D-The immunoglobulins Fc receptors: -epitope-engaged antibodies are recognized by phagocytic cells Fc receptors. -The Fc receptor that binds Ig. E is the exception.

N Examples on Immunoglobulin Fc receptors: Immune cell Receptor Effector Function Macrophage, Neutrophils, and Eosinophils. FcγR I FcαR I -Uptake, and Stimulation. -Induction of Killing Mast Cell Basophils FcεRI Degranulation.

N E-The Natural Killer cell receptors: 1 -Killer activation receptors (KARs): -Recognize the presence of Stress-related molecules (MICA and MICB) expressed by the unhealthy host cells. 2 -Killer inhibition receptors: (KIRs): -Recognize the presence of MHC class I , which is normally displayed on the host cell surfaces.

N 2 -Somatically generated receptors: A-B cell receptors (BCR): -Immunoglobulins serve as B-cell receptors. -Two Igα and Igβ chains initiate intracellular signaling cascade; due to binding of antibody to its epitope. B-T cell receptors (TCR): -Cluster of differentiation 3 (CD 3). -Binds to MHC. -CD 4 and CD 8 are co-receptors.
- Slides: 16